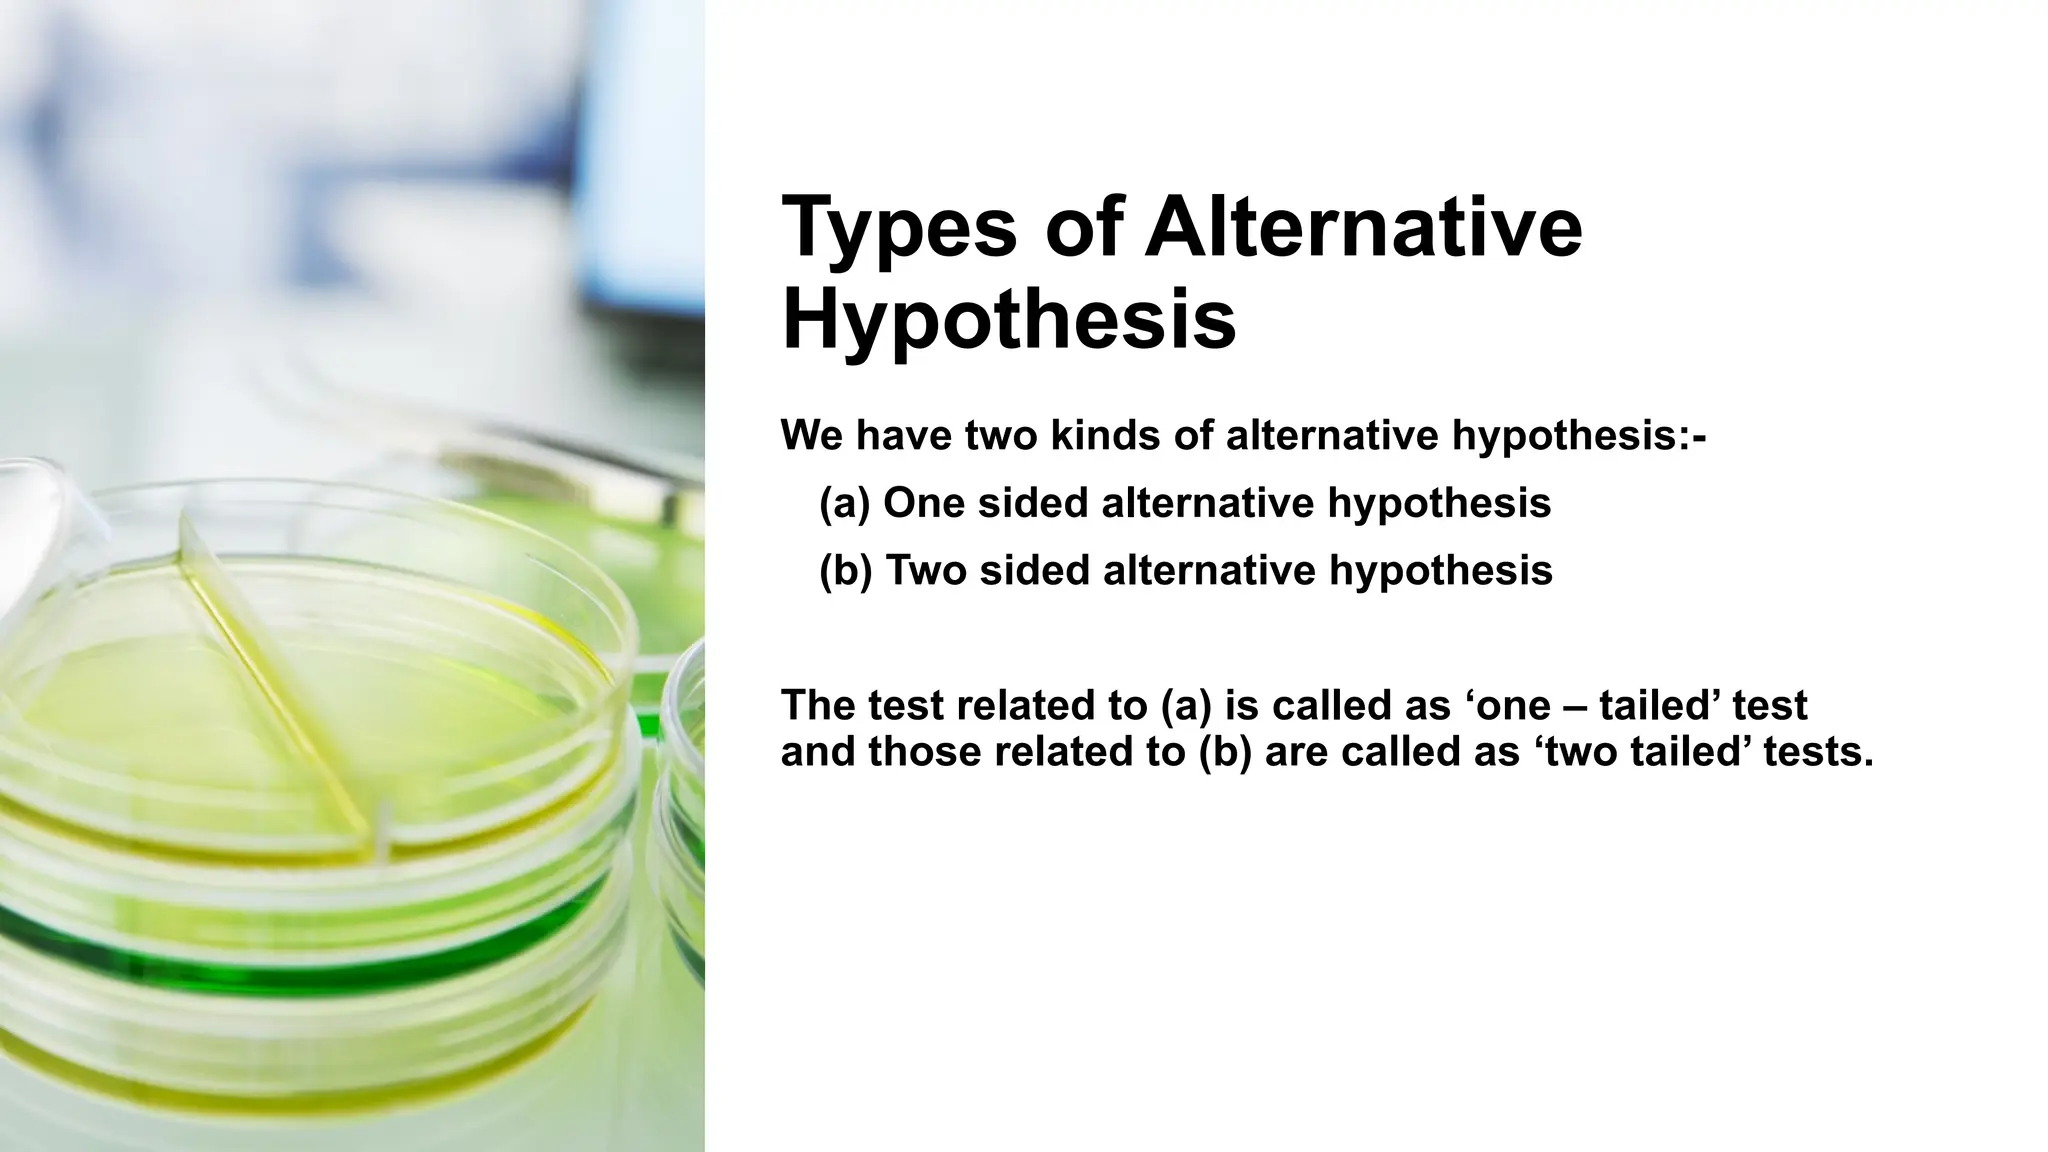
Types of Alternative
Hypothesis
We have two kinds of alternative hypothesis:-
(a) One sided alternative hypothesis
(b) Two sided alternative hypothesis
The test related to (a) is called as ‘one – tailed’ test
and those related to (b) are called as ‘two tailed’ tests.

The document discusses hypothesis testing and inference, defining a hypothesis as a testable prediction regarding research outcomes, and outlining characteristics of good hypotheses. It elaborates on types of hypotheses, specifically null and alternative, detailing their roles in statistical decision-making, including test statistics, significance levels, and errors such as Type I and Type II. Additionally, it compares parametric and non-parametric testing methods and suggests approaches for selecting appropriate statistical tests based on data distribution and sample size.